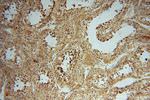
PAN2 Antibody in Immunohistochemistry (Paraffin) (IHC (P))
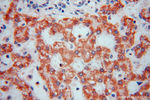
PAN2 Antibody in Immunohistochemistry (Paraffin) (IHC (P))

Search
Proteintech
PAN2 Polyclonal Antibody
{{$productOrderCtrl.translations['antibody.pdp.commerceCard.promotion.promotions']}}
{{$productOrderCtrl.translations['antibody.pdp.commerceCard.promotion.viewpromo']}}
{{$productOrderCtrl.translations['antibody.pdp.commerceCard.promotion.promocode']}}: {{promo.promoCode}} {{promo.promoTitle}} {{promo.promoDescription}}. {{$productOrderCtrl.translations['antibody.pdp.commerceCard.promotion.learnmore']}}
产品信息
16427-1-AP
种属反应
已发表种属
宿主/亚型
分类
类型
抗原
偶联物
形式
浓度
规格
纯化类型
保存液
内含物
保存条件
运输条件
产品详细信息
Immunogen sequence: ATVVHILDS RTGGSLVAHI KVGETYHQRK EGVTHQQWYL FNDFLIEPID KHEAVQFDMN WKVPAILYYV KRNLNSRYNL NIKNPIEASV LLAEASLARK QRKTHTTFIP LMLNEMPQIG DLVGLDAEFV TLNEEEAELR SDGTKSTIKP SQMSVARITC VRGQGPNEGI PFIDDYISTQ EQVVDYLTQY SGIKPGDLDA KISSKHLTTL KSTYLKLRFL IDIGVKFVGH GLQKDFRVIN LMVPKDQVLD TVYLFHMPRK RMISLRFLAW YFLDLKIQGE THDSIEDART ALQLYRKYLE LSKNGTEPES FHKVLKGLYE KGRKMDWKVP EPEGQTSPKN AAVFSSVLAL (850-1198 aa encoded by BC024043)
靶标信息
This gene encodes a coregulator for the alpha and beta estrogen receptors and the orphan nuclear receptor NR1D2. The protein localizes to the nucleus, and is thought to have both coactivator and corepressor functions. Its interaction with nuclear receptors is independent of the AF2 domain on the receptors, which is known to regulate interaction with other coreceptors. Two alternatively spliced transcript variants for this gene have been described. However, the full length nature of one of the variants has not been determined.
仅用于科研。不用于诊断过程。未经明确授权不得转售。
生物信息学
蛋白别名: AN2 polyA specific ribonuclease subunit homolog; Inactive ubiquitin carboxyl-terminal hydrolase 52; inactive ubiquitin carboxyl-terminal hydrolase 52 {ECO:0000255|HAMAP-Rule:MF_03182}; PAB-dependent poly(A)-specific ribonuclease subunit 2; PAB-dependent poly(A)-specific ribonuclease subunit PAN2; PAB-dependent poly(A)-specific ribonuclease subunit PAN2 {ECO:0000255|HAMAP-Rule:MF_03182}; PAB1P-dependent poly(A)-nuclease; PAB1P-dependent poly(A)-nuclease {ECO:0000255|HAMAP-Rule:MF_03182}; PAB1P-dependent poly(A)-specific ribonuclease; PABP-dependent poly(A) nuclease 2; PAN deadenylation complex catalytic subunit 2; PAN deadenylation complex catalytic subunit 2 {ECO:0000255|HAMAP-Rule:MF_03182}; PAN deadenylation complex subunit 2; PAN2 poly(A) specific ribonuclease subunit homolog; PAN2 polyA specific ribonuclease subunit homolog; PAN2-PAN3 deadenylation complex catalytic subunit PAN2; Poly(A)-nuclease deadenylation complex subunit 2; ubiquitin specific peptidase 52; ubiquitin specific protease 52; unnamed protein product
基因别名: 1200014O24Rik; AI047843; AW742773; KIAA0710; mKIAA0710; PAN2; USP52
UniProt ID: (Human) Q504Q3, (Mouse) Q8BGF7
Entrez Gene ID: (Human) 9924, (Rat) 408200, (Mouse) 103135